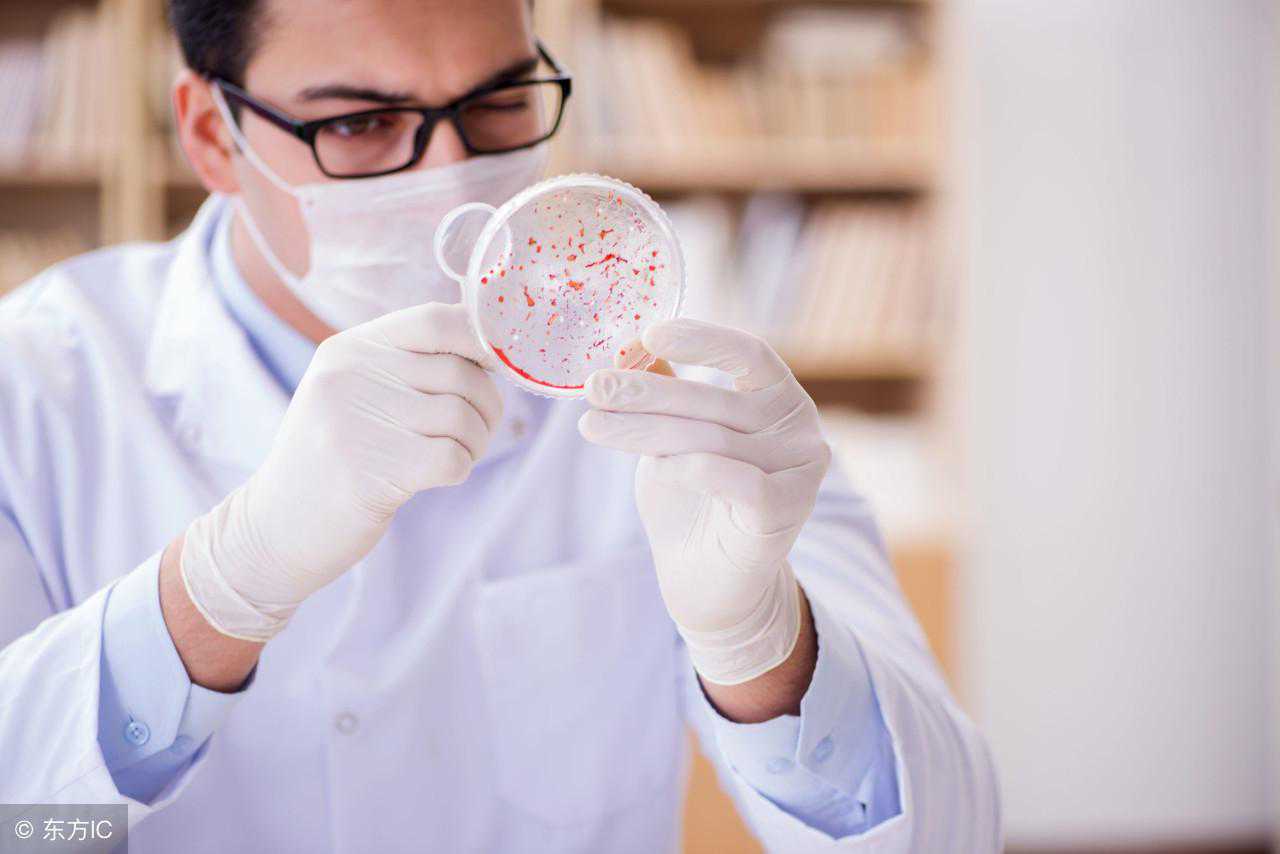

正常情况下试管婴儿一般是患者自己的,但是患者精子活力不强或者无生育能力,患者可向医院提出捐精申请,从医院精子库中抽选质量较优的精子,捐精者信息属于隐私。当然,对于一些特殊要求的患者,还可以指定捐精对象。
一、试管婴儿用的是谁的精子

1、通常来讲,做试管婴儿手术时,如果男方自己能射精,可以通过手淫造成射精,用试管取精子的,如果是男方无射精能力,可以用注射器抽吸来获取精子。
2、若是在男性睾丸中实在找不到健康有活力的精子,可以把男性的精原细胞取出,在实验室培养出精子来。不过这样费用极高。
3、或者是向医院提出申请,可以从医院精子库里面选取精子,捐精人信息保密。
二、试管婴儿取精子的方式
1、在男性患者手淫取精过程中,患者一定要用清水洗干净双手、阴茎、外阴等,然后手淫时留取精液,注意一定要给玻璃贮存杯进行无菌消毒过,留取时不要触摸杯体边缘及杯内,精液一定要保持体温温度。
2、如果当事人在母体取卵当天不能通过手淫的方法顺利取精,那就必须通过附睾穿刺或者睾丸活检取精,然后将取得的精子与女性的卵子受精。
3、一般来讲市面上常见的避孕套内含有杀精成分,会对精液质量造成影响,因此要想通过此方法获得鲜活的精子,需采用特制的避孕套,在性交后,从避孕套内获得精液,即刻送往生殖中心。
三、试管婴儿的取精前后注意事项

1、取精前,为保证精液质量,需禁欲一个月,男性必须要提前三个月左右,戒烟戒酒,不能熬夜,注意休息。
2、取精当日,需洗干净双手,清洁干净外阴、阴茎、包皮内的污垢。
3、取精时,用洗手液认真洗净双手,阴茎切勿触摸到杯缘和杯内,同时避免阴毛、衣服纤维,灰尘等落入杯内,取集后立即盖好杯盖传递医院。试管婴儿取精过程麻烦,必须谨慎,需要谨遵医嘱,试管婴儿手术要求极其严格。
遵守术前检查和正式试管婴儿试验周期操作,患者不必因为手术而过分担心,保持良好的心态。正常来说试管婴儿一般是患者自己的,但是如果患者精子活力不强或者无生育能力,患者可向医院提出捐精申请,从医院精子库中抽选质量较优的精子,捐精者信息属于隐私。


















